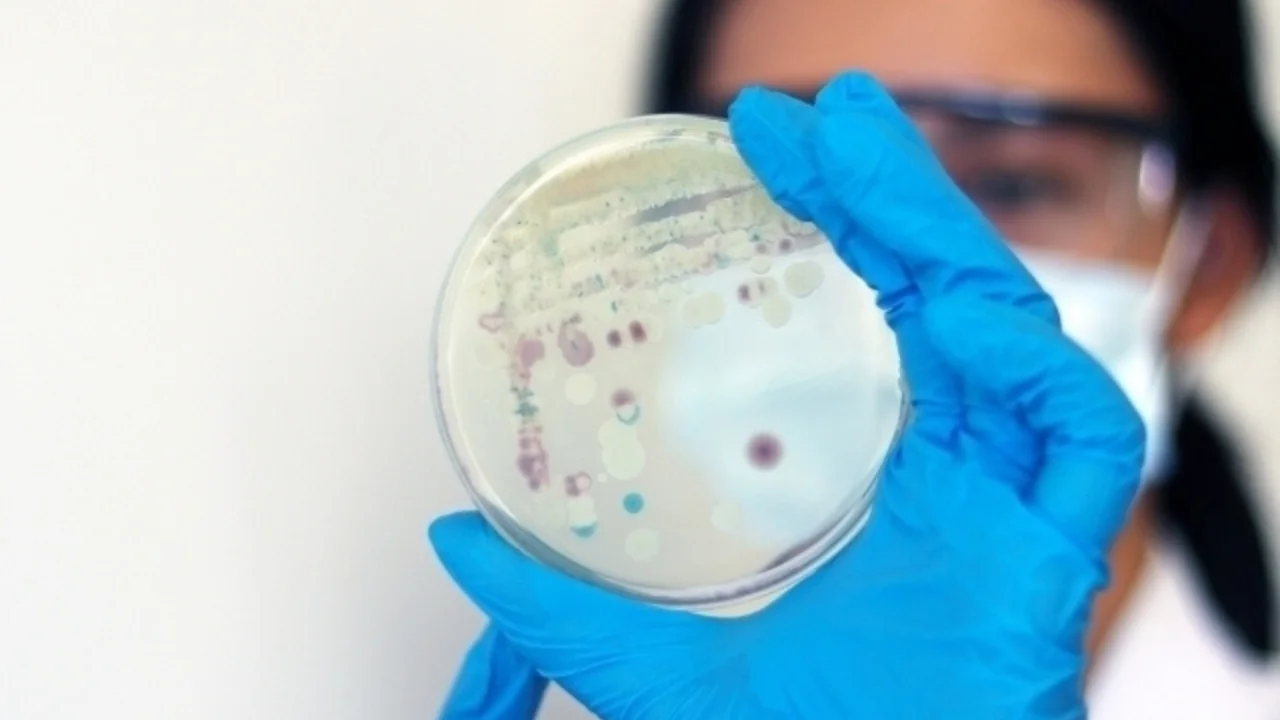
Ерда 407 миллион йиллик қадимий замбуруғ топилди

Ерда 407 миллион йиллик қадимий замбуруғ топилди
Kembrij universiteti qoshidagi Seynsberi laboratoriyasi olimlari Shotlandiyada 407 million yil avval yashagan zamburug‘ qoldig‘ini topishdi, deb yozdi New Phytologist.
Topilma Uinfild slanes tosh qatlamlaridan aniqlangan bo‘lib, u zamburug‘lar va o‘simliklar o‘rtasidagi ilk biologik hamkorlik — mikoriza mavjudligini tasdiqladi. Bu o‘zaro foydali ittifoqda zamburug‘lar o‘simliklarga suv va mineral moddalarni o‘zlashtirishda yordam bersa, o‘simliklar esa ularga shakar moddalarini taqdim etgan. Mikoriza bugungi ko‘plab ekotizimlar uchun asosiy biologik tizim hisoblanadi.
Yangi tur Rugososporomyces lavoisierae deb nomlandi. U qadimgi Aglaophyton o‘simligi bilan simbiotik munosabatda bo‘lgan va mazkur o‘simlikka bog‘liq ikkinchi zamburug‘ turi sifatida qayd etildi.
Olimlar qotib qolgan to‘qimalarni zamonaviy mikroskopiya orqali o‘rganib, zamburug‘ va o‘simlik hujayralarini aniq ajrata oldi. Ular hatto DNK saqlanmaganiga qaramasdan, optik izlar orqali zamburug‘ mavjudligini isbotladi.
Tadqiqot rahbari, doktor Kristin Strullu-Derriyen ta’kidlashicha, zamburug‘ning tarmoqli tuzilishi uning parazit emas, balki o‘simlik bilan hamkorlikda yashaganini ko‘rsatgan.
“Bu kashfiyot Yerdagi hayot shakllanishida zamburug‘lar va o‘simliklar qanday qilib birgalikda quriq muhitga moslashganini va ilk ekotizimlarni yaratganini anglashda muhim ahamiyatga ega,” — deydi u.
“Zamin”ni Telegramʻda oʻqing!